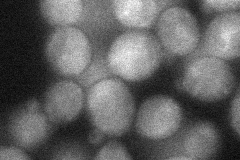
YPL243W
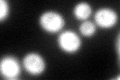
YPL243W
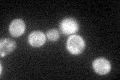
YPL243W

View description
Core component of the signal recognition particle (SRP) ribonucleoprotein (RNP) complex that functions in targeting nascent secretory proteins to the endoplasmic reticulum (ER) membrane
Localization:
Intensity:
Fold change:
Significance:
-
C’ GFP library in SD

cytosol79.99 -
N' NOP1pr-GFP in SD

ER,nucleolus85.9313 -
N' TEF2pr-mCherry in SD

nucleus,nucleolus46.5408 -
N' NATIVEpr-GFP in SD

ER74.5755 -
N' TEF2pr-VC and Cyto-VN in SD
cytosol33.2845 -
C’ GFP library in SD+DTT
cytosol79.440.99No -
C’ GFP library in SD+H2O2

cytosol91.541.14No -
C’ GFP library in Starvation Media
cytosol58.080.72No -
C’ GFP library on the background of Pup2-DaMP

cytosol -
C’ GFP library on the background of CCT mutant

cytosol100.851.26072No
